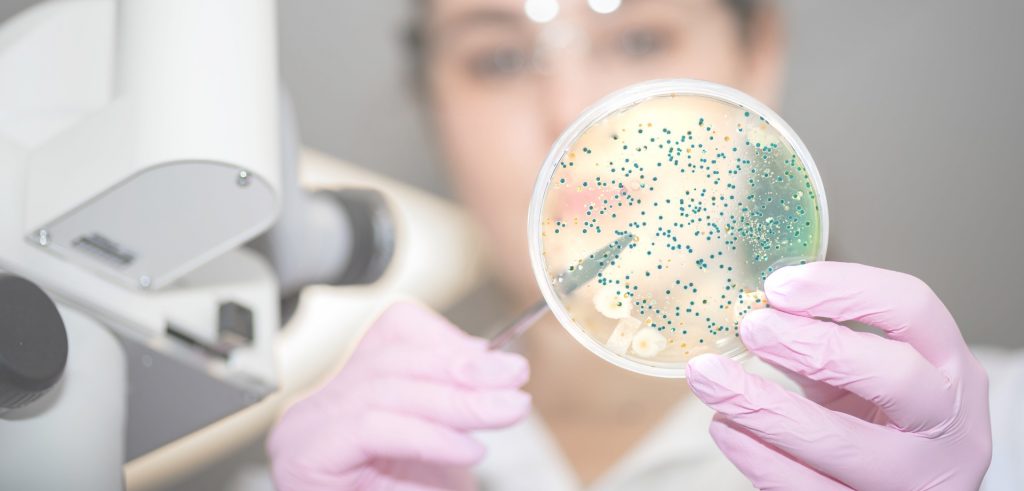
kompetencni centrum

Institut AllergoSan
Institut AllergoSan je inovativní, rychle se rozvíjející společnost s vedoucím postavením na trhu, která se již přibližně 30 let zabývá výzkumem a vývojem produktů, jejichž suroviny poskytuje sama příroda. Ať už se jedná o probiotika, bylinné látky nebo ortomolekulární medicínu, vždy je pro nás důležité nabízet našim zákazníkům vědecké poznatky, které jsou oddané celkovému lidskému systému a přírodě.
Obsah
Jak to vše začalo
Institut AllergoSan byl založen v roce 1991. Zrodil se z nápadu 20 lékařů, kteří potřebovali pro své pacienty alergologicky „čisté“ potraviny a léky a vyhledali pomoc lékárníka Friedricha Frauwallnera. Většina našich zákazníků v té době již léta bojovala s chronickými kožními onemocněními, jako je neurodermatitida a lupénka, a nyní náhle nalezla úlevu od svého trápení.
V roce 1992 převzala vedení institutu prof. Anita Frauwallner a prosadila speciální celostní lékařský přístup, totiž že zdraví člověka je zásadně podmíněno zdravým trávením. Již v roce 1993 byla vedle potravin bez alergenů a ortomolekulárních doplňků stravy zavedena první probiotika. V roce 1995 následovalo první probiotikum pod značkou OMNi-BiOTiC®.